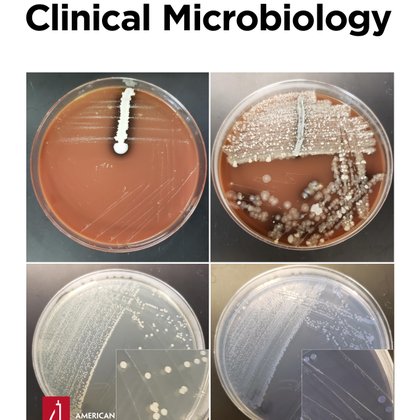
Tweet card summary image

icddr,b
@icddr_b
Followers
23K
Following
4K
Media
2K
Statuses
8K
International health research institute addressing #publichealth challenges • #infectiousdiseases #healthsystems #nutrition #vaccines #Bangladesh
Dhaka, Bangladesh
Joined January 2012
🚨 Breaking News! We’re proud to share that MDCF-2, developed by researchers from icddr,b and @WashU has been acknowledged in @TIME’s Best Invention of 2025 under the Social Impact category! 🔗Read more: https://t.co/TuEuCEpbEv
#TIMEBestInventions2025 #MDCF2
time.com
Find out why MDCF-2 is on TIME's list of 2025's best inventions.
0
2
5
A recent metagenomic study from icddr,b detected pathogenic bacteria containing antimicrobial resistance genes in floodwaters from four districts of Bangladesh in 2024, suggesting increased risk of waterborne disease during seasonal flooding. https://t.co/lnX5ZlDu90
enviromicro-journals.onlinelibrary.wiley.com
Metagenomic analysis of Bangladesh floodwaters reveals diverse pathogens (Klebsiella pneumoniae, Pseudomonas aeruginosa), antimicrobial resistance genes (blaOXA, ermB), and mobilizable plasmids...
0
0
0
🤰🏾 Global Nutrition Expert Calls for Early MMS Intake at icddr,b Day 2025 Observance At a special seminar marking icddr,b’s 65th anniversary, global nutrition expert Prof. Keith P. West Jr (@JohnsHopkinsSPH) highlighted how early nutritional support can decisively improve
0
0
2
What was once leftover fabric could become your new favorite. In 2024, SHEIN and Aloqia transformed 28,000 meters of deadstock into new styles, saving resources and reducing waste. Join us as we move towards a circular fashion future—every step counts.
2
6
65
📣 Global experts joined icddr,b for the Annual Scientific Advisory Group meeting. The two-day discussions covered innovation, climate and health, SRHR, infectious and non-communicable diseases, maternal and child health, nutrition, and stronger lab and clinical services. SAG
0
1
3
🧫World Antimicrobial Resistance Awareness Week 2025. Taking antibiotics unnecessarily, in excess, or without following proper guidelines increases antimicrobial resistance. As a result, treating bacterial infections is becoming extremely difficult. If this continues, one day no
0
0
0
💬Around her underweight baby's first birthday, Salma learned about #MDCF-2 (Microbiota-Directed Complementary Food), a gut-restoring food developed by @icddr_b for #malnourished #children. Their Mirpur branch is just a five-minute walk from her home. News of the new trial spread
tbsnews.net
In neighborhoods where hunger speaks loudly, MDCF-2, the small sachet of fortified paste developed by icddr,b, became a beacon of hope. Recently, it was named one of TIME’s Best Inventions of 2025 in
0
1
2
A new study — from a global team including icddr,b researchers — reports promising results from a trial of a novel vaccine against the diarrheal pathogen Shigella in an animal model, supporting further development of the vaccine and possibly human trials. https://t.co/DUjCVNjkkD
0
2
7
Wastewater surveillance can reveal an uptick in typhoid-causing bacteria 13 days before the rise of clinical cases. If applied to launching targeted typhoid vaccination campaigns, it could massively reduce hospitalizations, deaths, and associated costs. https://t.co/fdRlvaKzXz
link.springer.com
Tropical Diseases, Travel Medicine and Vaccines - Enteric diseases are a leading cause of mortality in developing countries, yet are highly preventable. Typhoid vaccines remain underutilized, and...
0
2
3
🎥 What is Microbiota-Directed Complementary Food (MDCF-2)?How can it help restore gut health and promote growth in undernourished children? Dr Tahmeed Ahmed, Executive Director of icddr,b, explains.📷Watch here: https://t.co/VeXFs1Ittf
#TIMEBestInventions2025 #icddrb #MDCF2
0
2
5
🥣If the gut microbiome influences obesity, could it also hold the key to undernutrition? —a discussion between two scientists from @icddr_b and @WashU led to #MDCF2, now helping undernourished children worldwide. Read more: https://t.co/7RpUOfHlQ1
#TIMEBestInventions2025 #icddrb
icddrb.org
In the 21st century, the idea of a community of bacteria coexisting with our bodies is not a remote concept to an ever-increasing proportion of the population. This reflects the growing body of...
0
2
4
Across eight countries, asymptomatic infections of the diarrheal pathogen Cryptosporidium occurred at a rate of 7.89 per 100 child-months, and were linked to stunting, wasting, and underweight — icddr,b scientists report in a new analysis of the MAL-ED (Malnutrition and Enteric
link.springer.com
BMC Nutrition - Subclinical or asymptomatic cryptosporidiosis can contribute to malnutrition in children, especially in environments where the infection is persistent or occurs repeatedly. Despite...
0
0
3
🥣If the gut microbiome influences obesity, could it also hold the key to undernutrition? —a discussion between two scientists from @icddr_b and @WashU led to #MDCF2, now helping undernourished children worldwide. Read more: https://t.co/7RpUOfHlQ1
#TIMEBestInventions2025 #icddrb
icddrb.org
In the 21st century, the idea of a community of bacteria coexisting with our bodies is not a remote concept to an ever-increasing proportion of the population. This reflects the growing body of...
0
2
4
🎥 What is Microbiota-Directed Complementary Food (MDCF-2)?How can it help restore gut health and promote growth in undernourished children? Dr Tahmeed Ahmed, Executive Director of icddr,b, explains.📷Watch here: https://t.co/VeXFs1Ittf
#TIMEBestInventions2025 #icddrb #MDCF2
0
2
5
🏃♀️ Join the Bonita Stanton, M.D., Memorial 5K! icddr,b proudly sponsors this race honoring Dr Bonita Stanton’s legacy & supporting future physicians. 🗓 5 October 2025 | ⏰ 7:30–11:00 AM 📍 Brookdale Park, Watchung Ave, Bloomfield, NJ 07003 ➡️ Register: https://t.co/6QEHVFazAY
0
0
2
A new @PLOSGPH study sheds light on the mental health impact of extreme climate events, showing that flooding of compounds and latrine flooding are associated with higher depression among pregnant women living in riverine communities in rural Bangladesh. https://t.co/2anUsebtKZ
journals.plos.org
Prenatal depression can have lasting adverse impacts on child health. Little is known about the impact of floods on prenatal depression in low- and middle-income countries. We conducted a cross-sec...
0
0
0
Moderate to severe malnutrition is a more important risk factor for mortality than aflatoxin in acutely ill children, but aflatoxin exposure increases risk of mortality in the absence of acute malnutrition. Read more: https://t.co/UdlPPJMSVX
gh.bmj.com
Background Chronic exposure to aflatoxins is associated with liver cancer, impaired child growth, and compromised immune function. The Childhood Acute Illness and Nutrition (CHAIN) Network cohort was...
0
0
2
A new study identified 4 bacterial species that were significantly lower in abundance in typhoid fever patients compared with asymptomatic household contacts in Bangladesh & Malawi, suggesting they may protect against clinical infection following exposure to Salmonella Typhi.
In #Microbiome 🔍Investigating the links between the gut microbiome & typhoid fever 🚨Identifying 28 specific metabolic gene clusters negatively associated with typhoid fever, including 7 involved in SCFA metabolism 👉 https://t.co/f8j5AhYcKq
0
2
0
EXW vs. FOB vs. DDP shouldn’t slow a shipment down. Download the Incoterms 2020 cheat sheet and get clarity in 2 minutes. → Click for free download
3
3
40
Sequencing-based analysis of Bangladeshi patients with Rett syndrome-like features revealed 51.9% carried mutations in the MECP2 gene, which is known to be linked to Rett syndrome, and identified 6 novel candidate genes linked to Rett-like symptoms. https://t.co/DyhzzE7JUc
0
0
0
A recent study showed that rapid diagnostic tests (RDTs) can replace traditional slide agglutination methods to confirm Vibrio cholerae colonies belonging to the dominant O1 serogroup, providing a cheaper & faster alternative in resource-limited settings. https://t.co/N36X4LBfYQ
journals.asm.org
This study demonstrated that rapid diagnostic tests (RDTs) can effectively replace traditional slide agglutination methods to confirm suspected Vibrio cholerae colonies belonging to the O1 serogroup,...
0
1
2
Stakeholders once again urge #Bangladesh to add the #rotavirus #vaccine to its National Immunisation Programme, citing the urgent need to protect children from severe diarrhoea and save thousands of young lives each year. 👉 https://t.co/iOc3IJsVDB
0
0
5